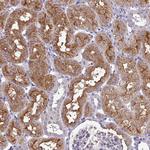
KCTD16 Antibody in Immunohistochemistry (Paraffin) (IHC (P))

Search
Invitrogen
KCTD16 Polyclonal Antibody
{{$productOrderCtrl.translations['antibody.pdp.commerceCard.promotion.promotions']}}
{{$productOrderCtrl.translations['antibody.pdp.commerceCard.promotion.viewpromo']}}
{{$productOrderCtrl.translations['antibody.pdp.commerceCard.promotion.promocode']}}: {{promo.promoCode}} {{promo.promoTitle}} {{promo.promoDescription}}. {{$productOrderCtrl.translations['antibody.pdp.commerceCard.promotion.learnmore']}}
产品信息
PA5-62146
种属反应
宿主/亚型
分类
类型
抗原
偶联物
形式
浓度
规格
纯化类型
保存液
内含物
保存条件
运输条件
RRID
产品详细信息
Immunogen sequence: PQETVICGPV TRQTNIQTLD RPIKKGPVQL IQQSEMRRKS DLLRTLTSGS RESNMSSKKK AVKEKLS
Highest antigen sequence identity to the following orthologs: Mouse - 96%, Rat - 27%.
靶标信息
The BTB (Broad-Complex, Tramtrack and Bric a brac) domain, also known as the POZ (Poxvirus and Zinc finger) domain, is an N-terminal homodimerization domain that contains multiple copies of kelch repeats and/or C2H2-type zinc fingers. Proteins that contain BTB domains are thought to be involved in transcriptional regulation via control of chromatin structure and function. KCTD16 (potassium channel tetramerisation domain containing 16), also known as BTB/POZ domain-containing protein KCTD16, is a 428 amino acid protein that contains one BTB (POZ) domain. An auxiliary subunit of GABAB R1 and GABAB R2, KCTD16 increases agonist potency and alters the G-protein signaling of the receptors by accelerating onset and promoting desensitization.
仅用于科研。不用于诊断过程。未经明确授权不得转售。
篇参考文献 (0)
生物信息学
蛋白别名: BTB/POZ domain-containing protein KCTD16; potassium channel tetramerisation domain containing 16; Potassium channel tetramerization domain-containing protein 16; unnamed protein product
基因别名: KCTD16; KIAA1317
UniProt ID: (Human) Q68DU8
Entrez Gene ID: (Human) 57528